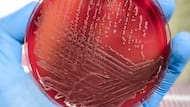

La Administración de Alimentos y Medicamentos de Estados Unidos (FDA) alertó sobre el retiro voluntario de barras de chocolate de la marca Spring & Mulberry debido a una posible contaminación con Salmonela.
El anuncio inicial del 12 de enero de 2026 afectaba a un solo producto, pero la empresa amplió la medida el 15 de enero para incluir ocho variedades diferentes de chocolate que fueron producidas en el mismo periodo y con el mismo equipo.
La decisión de expandir el retiro responde a la naturaleza impredecible de la bacteria: “Como la Salmonela puede ser difícil de detectar y puede aparecer de manera intermitente, ahora estamos expandiendo el retiro más allá de Mint Leaf en consulta con la FDA para incluir lotes de producción adicionales fabricados durante el mismo período en el mismo equipo”, explicó la compañía con sede en Raleigh, Carolina del Norte.
Hasta el momento, no se han reportado casos confirmados de enfermedades relacionadas con el consumo de estos productos.
Cuáles son los productos afectados y cómo identificarlos para evitar su compra
El retiro inicial incluyó únicamente la barra Mint Leaf Date Sweetened Chocolate Bar de 60 gramos (2.1 onzas) del lote número 025255. Sin embargo, la ampliación del retiro ahora abarca siete sabores adicionales:
- Earl Grey
- Lavender Rose
- Mango Chili
- Mixed Berry
- Mulberry Fennel
- Pecan Date
- Pure Dark Minis.
Los productos afectados se distribuyen bajo 16 códigos de lote diferentes: 025258, 025259, 025260, 025283, 025255, 025275, 025281, 025337, 025345, 025261, 025265, 025267, 025268, 025339, 025343 y 025273.
Los chocolates pueden identificarse por la marca Spring & Mulberry impresa en el empaque, el color característico de cada variedad y, principalmente, por el código de lote ubicado en la parte posterior de la caja y en el envoltorio interior de plástico transparente.

La barra original retirada, de sabor Mint Leaf, viene en una caja de color verde azulado. Estos productos estuvieron disponibles para su compra en línea y en distribuidores minoristas seleccionados en todo Estados Unidos desde el 15 de septiembre de 2025.
El chocolate fue retirado de todos estos comercios en USA
El sitio web de Spring & Mulberry indica que sus chocolates se comercializan en tiendas especializadas, supermercados, grandes almacenes, hoteles y tiendas de regalos locales en todo el país.

La empresa utiliza múltiples canales de distribución que incluyen tanto plataformas digitales como establecimientos físicos en diversos estados. La posible contaminación fue detectada después de que un laboratorio externo realizara pruebas de rutina sobre productos terminados, lo que activó el protocolo de seguridad alimentaria de la compañía.
Qué hacer si adquirió el producto
La FDA y Spring & Mulberry instruyeron a los consumidores que hayan adquirido cualquiera de los lotes afectados a no consumir el producto y desecharlo de inmediato.
Los clientes pueden solicitar un reembolso completo o un producto de reemplazo contactando a la empresa a través del correo electrónico recalls@springandmulberry.com. Para procesar la solicitud, se debe enviar una fotografía del código de lote visible en el empaque.
“Los clientes que hayan comprado los lotes afectados listados anteriormente no deben consumir los productos y deben desecharlos inmediatamente”, enfatizó la compañía en su comunicado oficial.
Cuáles son los riesgos de la Salmonela para la salud
La Salmonela es una bacteria que puede provocar infecciones serias y, en algunos casos, mortales, particularmente en:
- niños pequeños
- personas mayores o frágiles
- aquellos con sistemas inmunitarios debilitados.
Cuáles son los primeros síntomas de la Salmonela
Las personas sanas infectadas con Salmonela pueden experimentar fiebre, diarrea (que puede ser con sangre), náuseas, vómitos y dolor abdominal, según advierte la FDA en su comunicado oficial.